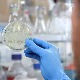
Шта треба да знате ако желите да проверите антитела после вакцине

Коронавирус у Србији
недеља, 21. мар 2021, 19:38 -> 19:58
Влада усвојила нове мере – шта од понедељка остаје закључано, а шта може да ради и под којим условима
Влада Србије саопштила је да од понедељка у 6 ујутро остају затворени угоститељски објекти и тржни центри. Објекти продаје хране и установе културе могу да раде до 21 час, а сви остали објекти до 20 часова...
недеља, 21. мар 2021, 18:02 -> 19:08
Нове мере Кризног штаба – тржни центри и угоститељски објекти остају закључани
Кризни штаб одлучио је да рад од сутра у 06.00 буде омогућен свима осим тржним центрима и угоститељским објектима, уз максимално поштовање мера...
недеља, 21. мар 2021, 17:50 -> 18:00
Шта треба да знате ако желите да проверите антитела после вакцине
Најбоље време да се провере антитела је две недеље после ревакцине, али треба се добро распитати који тест урадити како би показао праву слику, рекла је докторка Марија Гњатовић из Института за примену...
недеља, 21. мар 2021, 16:50 -> 22:14
Старешина Храма Светог Саве позива вернике да се вакцинишу
Викарни епископ ремезијански владика Стефан позвао је све вернике да се вакцинишу против ковида 19...
недеља, 21. мар 2021, 15:00 -> 15:21
Пресек за последња 24 сата – преминула 34 пацијента, коронавирусом заражено још 4.232
Према последњем пресеку, у Србији је од последица ковида преминуло још 34 особа. Од тестираних 12.442, на коронавирус је позитивно 4.232 особа...
недеља, 21. мар 2021, 13:47 -> 13:59
Лончар за руске Вести ТВ: Србија се сама борила за вакцине
Министар здравља Златибор Лончар истакао је у интервјуу за националну телевизију Руске федерације, Вести ТВ, да се Србија у погледу набавке вакцина ослањала на своје ресурсе и сама се борила за вакцине...
недеља, 21. мар 2021, 09:19 -> 09:19
Др Михајловић: Расте број ковид позитивних трудница, мислим да су се опустиле
Начелница Болнице за гинекологију и акушерство Клиничко-болничког центра "Др Драгиша Мишовић" Слађана Михајловић каже да расте број ковид позитивних трудница које развијају све теже клиничке слике...
недеља, 21. мар 2021, 08:30 -> 10:02
Радојичић: Нове мере се боље поштују него пре, враћам се на мантру - солидарност и одговорност
Инспекције и Комунална милиција појачано контролишу спровођење мера. Градоначелник Београда Зоран Радојичић рекао је за РТС да грађани различито реагују на страх али да је понашање ирационално. Нове мере...
недеља, 21. мар 2021, 08:27 -> 08:41
Јанковић: Људи играју руски рулет са својим здрављем, ово неће скоро стати
Притисак на ковид објекте у Нишу ће расти, а људи више и не знају где су се заразили, каже за РТС професор др Радмило Јанковић, заменик директора Клиничког центра у Нишу. Сматра да апели неће имати таквог...
недеља, 21. мар 2021, 06:54 -> 07:45
Доктор из Хитне: Као да снимамо ратни филм - а играње кола, терање ината и шеге не знам чему служи
Изгибосмо и ми у Хитној и сви остали доктори, рекао је за РТС доктор Александар Стијачић, коментаришући епидемиолошку ситуацију. Каже да сцене из болница подсећају на ратне филмове и позива оне који играју...

Коментари